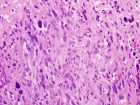
Zoom image: Cell stain

Case 8
D.R. - 65 year old male, c/o worsening right hip/buttock pain for six months. Pain is constant, worse with activity. Tylenol helps a bit. No F/C or constitutional sx.
PMH: Crohn's disease, nephrolithiasis, prostate infection, gallstones
Upcoming Events
Orthopaedic Dept PA Lecture Series
6:30 am - 7:30 am
Prviate Event at Maplemere Concussion Suite Dictation Room
6:30 am - 7:30 am
Prviate Event at Maplemere Concussion Suite Dictation Room
Import medical school events to your Exchange, Gmail, iPhone or iPod calendar. Customize your calendar by selecting different event categories and receive automatic reminders of the school events that matter most to you.